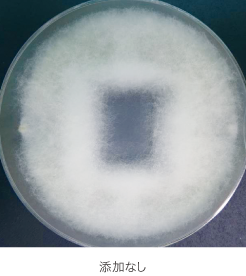
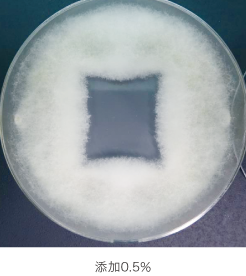

パシフィックビーム・モールド プレマエディション
塗料に添加するだけで
住まいの悩みを解決する
「PBM プレマエディション」
温暖多湿な我が国は、多くの種類のカビや細菌にとって適した環境にあり、
たとえ外壁塗装でカビや藻をきれいに除去しても
同じ環境下では、再発生することが多く
その美観を維持し続けることは非常に困難です。
PBM(パシフィックビーム・モールド) プレマエディションは、
使用する上塗り塗料に少量入れるだけで
日本の建物を悩ますカビ・菌・藻類に対し優れた効果を発揮。
僅かなオプションで塗料の性能が向上し、
大切な建物の美観を長期にわたり保持します。
パシフィックビーム・モールド プレマエディション
の特長
-
多菌種対応
検出頻度の高い57種のカビ・細菌を含む、全2,038種類もの菌・藻類に効果を発揮。
-
防カビ性
忌避効果と独自の複合技術によりカビ・細菌に対して抜群の抑制・防止効果を発揮。
-
防藻性
一般的な防カビ剤では対処しきれない藻類にも効果を発揮。
-
高持続性
成分が流出しづらいため、塗膜のカビ・細菌・藻類の発生を長期間防ぐ。
-
高安全性
SIAA登録商品として安全性と性能が認められた抗菌製品。※PBM ディスパージョン
-
高効率性
わずかな添加で効率よく優れた効果を得ることが可能。
世界トップクラスの
抗菌対応範囲
一般的な防カビ剤配合塗料の評価試験「JIS Z 2911(カビ抵抗性試験)」は、5種類のカビに対する抵抗評価であり、住宅で発生するカビに十分に対応できていないのが実情です。 また、一般的な防カビ剤でも30〜40種類のカビにしか抑制効果がないと言われています。 PBM プレマエディションは住宅で発生しやすい57種類のカビ・細菌を含む、全2,038種類の菌に対して効果を発揮します。
住宅で発生しやすいカビ・細菌57種に対応
PBM プレマエディションは、米国デンバーにある世界微生物災害防止学会で確認された、一般建設物から高い頻度で検出されるカビ・細菌の57種に対応しています。


カビとはなにか
カビは微生物の一種で「真菌」と呼ばれており、酵母やキノコも真菌として分類されています。真菌は糸状菌と酵母がありますが、建物に発生し被害をもたらすのはほとんど糸状菌です。建物の基質に胞子から菌糸を伸ばし、分枝して栄養体をつくり、気中に菌糸を出し、その先端や側面から胞子柄を直立し胞子を実らせます。菌の中でも最も強固とされています。

カビ・細菌・藻類が引き起こす住まいと人への影響
・建物の美観を大きく損ねる。 ・塗膜がカビや藻に含まれる水分に常態的に晒されることにより、加水分解を起こし早期劣化の要因となる。 ・深く浸透したり、広く増殖したり、固着する性質があるため、除去が難しい。 ・喘息やアレルギーなど、さまざまな健康被害を引き起こす可能性がある。
忌避効果がもたらす 3つのメリット
忌避効果は、死滅させるのではなく寄せ付けない仕組みであり、他社にはない独自のメリットがあります。
-
1
少量の添加で最大の効果
低い濃度でも抜群の効果を得ることができるため、コストを抑えつつ、塗料本来の性能に影響を与えることがありません。
-
2
耐性菌ができにくい
菌が死滅すると抵抗力を持った菌が増殖しますが、寄せ付けない仕組みが働くことで、死滅する菌を最小限にし、耐性を持つ菌の増殖を抑えます。
-
3
長期的な持続効果
忌避効果を持つ成分は非常に安定した化学構造を持ち、塗料に直接添加し撹拌することで塗膜形成後、長期にわたり有効成分を殆ど流出させません。
PBM プレマエディションの 忌避効果メカニズム
PBM プレマエディションは、独自の有機系成分の複合技術を利用し、菌の核の細胞壁を破壊します。また、菌を死滅させる過程で同種菌に忌避危険信号を送ることで、カビ・細菌が近づけない状態をつくり出します。
忌避効果により同種の菌を寄せ付けない
菌の核の
細胞壁(外套膜)を破壊

PBM プレマエディションは独自の有機系成分の複合技術により、2,000種類以上のカビ・細菌に対して、最も外側の細胞壁(外套膜)だけを破壊することができます。
菌の核を
仮死状態に

外套膜を破壊された菌は、タンパク質やDNA、SH基などの合成を阻害されてしまい、仮死状態となります。 その後も、生育に必要な栄養分などを得られなくなるため、やがて時間をかけながら死滅します。
仮死状態の菌が忌避効果
により 同種の菌を近づけない

仮死状態の菌は、死滅していくまでの間、 同種菌に対して近づかないよう危険信号を伝達します。同種菌はこれによってPBM プレマエディションがあるところには近寄らなくなります(忌避効果)。 「忌避信号伝達」の非接触型メカニズムによってカビ・細菌に対して抜群の抑制・防止効果を発揮します。
防カビ性
PBM プレマエディションは、上塗り塗料に少量を添加するだけで高い防カビ性能を発揮するため、塗料本来の性能を損ないません。 また、安定した化学構造は、経年による成分の流出を防ぎ、カビ・細菌の繁殖を長期にわたり抑えることができます。
かび抵抗性試験
メーカー推奨濃度(1%~)で使用することにより現場で圧倒的な効果を発揮します。

〈試験概要〉
- 試験方法
- タテイルアルファにPBM プレマエディションを添加し、添加量による防カビ効果の違いを比較
〈試験条件〉
- 菌種
- Trichoderma virens(NBRC 6355)
- 培養条件
- 暗所:25℃、4日間
- 試験基材
- 25×25mmポリスチレン板
非流出系のため長期的な持続効果を発揮
防カビ剤が配合されている塗料でも、有効成分は経年とともに流出し、その効果は失われていきます。PBM プレマエディションは非流出系のため塗膜からほとんど流出せずに、塗膜上のカビの発生を長期にわたり強力に抑制します。

〈試験概要〉
- 試験方法
- JIS Z 2911:2023 かび抵抗性試験 「9.塗料の試験」
〈試験条件〉
- 菌種
- Aspergillus niger NBRC 105649
- Penicillium pinophilum NBRC 6345
- Cladosporium sphaerospermum NBRC 6348
- Aureobasidium pullulans NBRC 6353
- Trichoderma virens NBRC 6355
- 培養条件
- 混合胞子懸濁液1mLを培養面と試験片に均等に吹付け、26℃で7日間培養
- 試験基材
- φ30mmろ紙
防藻性
PBM プレマエディションは、藻に対しても強力な抑制効果を発揮。
一般的な防藻・防カビ剤配合塗料では対処できない234種もの藻類に対して、 その発生を防ぎ長期にわたり建物の美観を保持します。
防藻試験
PBM プレマエディションを1%添加した塗膜は、培養3週間経過後も藻の発育を確実に抑制し、また防藻成分の溶出も見られません。
【タテイルアルファ】



〈試験概要〉
- 試験方法
- JIS Z 2911:2023に準拠
〈試験条件〉
- 菌種
- Chlorella vulgaris NIES-227
- 培養条件
- 株懸濁液を培養面と試験片に均等に吹き付け、26℃で3週間培養
- 試験基材
- スレート板
高い安全性と性能の証「SIAA」登録製品※PBM ディスパージョン
PBM ディスパージョンはSIAA(抗菌製品技術協議会)が定める安全性基準を満たした登録製品として認証されています。
【SIAAマークの3つの安心】



使用抗菌剤及び防カビ剤は、次の安全性試験などを確認したものを使用しています。

製品ラインナップ






